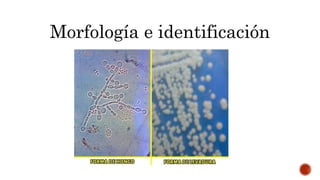
Morfología e identificación

Este documento describe las micosis por oportunistas causadas principalmente por especies del género Candida. Colonizan la piel y mucosas y pueden causar infecciones endógenas. Las formas sistémicas más comunes son C. albicans, C. tropicalis y C. parapsilosis. Pueden presentar resistencia a azólicos como el fluconazol. Se identifican morfológicamente como levaduras ovales que forman seudohifas y hifas. Causan candidiasis superficiales o sistémicas según el sitio